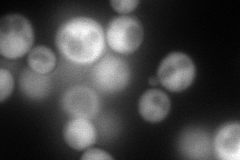
YFL007W
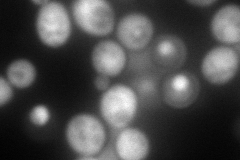
YFL007W
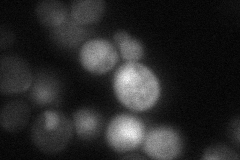
YFL007W
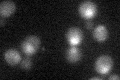
YFL007W

View description
Proteasome activator subunit; found in association with core particles, with and without the 19S regulatory particle; required for resistance to bleomycin, may be involved in protecting against oxidative damage; similar to mammalian PA200
Localization:
Intensity:
Fold change:
Significance:
-
C’ GFP library in SD

nucleus24.57 -
N' NOP1pr-GFP in SD
cytosol,nucleus151.924 -
N' TEF2pr-mCherry in SD
nucleus115.872 -
N' NATIVEpr-GFP in SD
nucleus29.543 -
N' TEF2pr-VC and Cyto-VN in SD

nucleus44.885 -
C’ GFP library in SD+DTT

nucleus23.090.93No -
C’ GFP library in SD+H2O2
nucleus24.61No -
C’ GFP library in Starvation Media

nucleusN/AN/AYes -
C’ GFP library on the background of Pup2-DaMP

nucleus -
C’ GFP library on the background of CCT mutant

nucleus18.37510.747466No
